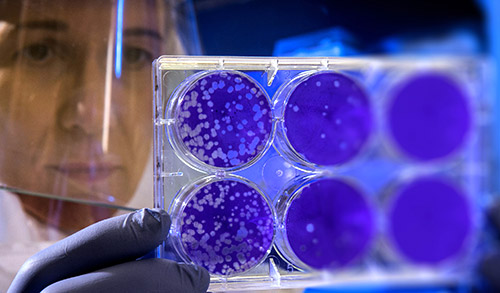

As winter began to wane this year, the world was upended by the COVID-19 pandemic. Unprecedented levels of interest in cell and gene therapies have followed, with research and development (R&D) facilities testing different potential solutions, such as immunoglobulin plasma treatments as part of vaccine trials. At the heart of these efforts, New Jersey’s biopharma industry has played a key role, inspiring collaboration, conducting research, and driving innovation.
In mid-March, New Jersey-headquartered biopharma companies Novartis and Bristol-Myers Squibb (BMS) both became major supporters of a collaborative cell and gene therapy coalition. The brainchild of BMS’ Rupert Vessey and Takeda Pharmaceutical Co. Ltd.’s Andrew Plump, the COVID R&D consortium is comprised of five working groups, with Novartis’ Jay Bradner leading the charge on novel small molecule antivirals. We’re very proud of the fact that our technology was born and raised in the state, and many of our employees are New Jersey natives. Dr. Robert Hariri, CEO & Founder, Celularity, Inc.
Several other entities within New Jersey are also hard at work for coronavirus research and manufacturing. Rutgers University researchers developed a saliva-based test for COVID-19 that could replace the nasal swab, as well as an at-home test kit. Rowan University biomedical engineers are studying how the SARS-CoV-2 spike protein affects the blood-brain barrier when the virus attaches to human cells. Hackensack University Medical Center rushed to study antibody-rich plasma therapy options for patients previously infected. Merck & Co., headquartered in Kenilworth, N.J., teamed up with New Jersey’s Hackensack Meridian to collaborate on research on COVID-19 at the health network’s Center for Discovery and Innovation in Nutley. Celularity Inc., in Warren, N.J., is currently researching two cell and gene therapies for COVID-19 and Acute Respiratory Distress Syndrome, the most damaging complication of the virus. It is estimated that over 60 New Jersey companies are currently developing COVID-19 treatments.
New Jersey's Life Sciences Industry
New Jersey's life sciences ecosystem supports the innovations being advanced by biopharmaceutical companies.
-
Novartis and Bristol-Myers Squibb
East Hanover, NJIn mid-March, New Jersey-headquartered biopharma companies Novartis and Bristol-Myers Squibb (BMS) both became major supporters of a collaborative cell and gene therapy coalition.
-
Hackensack University Medical Center
Hackensack, NJHackensack University Medical Center rushed to study antibody-rich plasma therapy options for patients previously infected.
-
Merck & Co
Kenilworth, NJMerck & Co., headquartered in Kenilworth, N.J., teamed up with New Jersey’s Hackensack Meridian to collaborate on research on COVID-19 at the health network’s Center for Discovery and Innovation in Nutley.
-
Celularity Inc.
Warren, NJCelularity Inc., in Warren, N.J., is currently researching two cell and gene therapies for COVID-19 and Acute Respiratory Distress Syndrome, the most damaging complication of the virus.
-
Hitachi Chemical
Allendale, NJRecently, Hitachi Chemical opened its Advanced Therapeutics Solutions facility in Allendale, N.J.
-
BioCentriq, New Jersey Institute of Technology
Collingswood, NJA key step forward for CGT research is the debut of BioCentriq, a cell and gene therapy production and manufacturing center.
-
Rowan University
Glassboro, NJRowan University is also well established in translational research for cell and gene therapy since 2001, when the Cell & Gene Therapy Center (CGTC) was founded.
-
Princeton Innovation Center Biolabs
Princeton, NJAt Princeton Innovation Center Biolabs, companies are given access to scalable shared office and lab space, and the opportunity to be a part of one of the world’s foremost academic epicenters.
-
The New Jersey Bioscience Center
North Brunswick Township, NJThe New Jersey Bioscience Center, owned and run by the New Jersey Economic Development Authority, offers a multitude of lab and office space options for companies at all stages of growth.
For those familiar with the life sciences sector, the vast amount of activity related to COVID-19 and CGT within the state should not be surprising. New Jersey is a robust life sciences hub, being:
- #1 in the U.S. with 139 FDA-registered biopharma manufacturing facilities
- #1 for employed biochemists and biophysicists
- #2 in biotech strength
- #2 region for National Institutes of Health funding
- #2 for cancer drugs in development
Multiple breakthroughs regarding cell and gene therapy have occurred over the years, including:
- Novartis: First ever CART-T cell therapy
- Celularity: CAR-T cell therapy for multiple myeloma
- Merck: Recombinant Ebola vaccine
- Advaxis: Cancer immunotherapy vaccine
- Caladrius: STEM cell therapy for critical limb ischemia
- PTC Therapeutics, Inc.: Pioneer of Duchenne muscular dystrophy (DMD) therapy
Higher Education Partnering with Industry
A key step forward for CGT research is the debut of BioCentriq, a cell and gene therapy production and manufacturing center. As a part of the biopharma division of the New Jersey Innovation Institute (NJII) and part of the New Jersey Institute of Technology in Newark, it is the only process development and clinical manufacturing facility for CGT on a university campus. With a combined 90+ years in manufacturing experience, the team at BioCentriq takes on projects from both industry titans and startups alike, with each solution customized to the challenge at hand. BioCentriq enables clients to outsource work that they normally couldn’t do in-house. Equally as valuable are the opportunities that NJIT is providing in workforce development and specialized education.
“We are one of the few universities in the country able to offer a Professional Science Masters (PSM) degree program and professional graduate certificate in the rapidly expanding field of cell and gene therapy,” stated Dr. Kevin D. Belfield, Dean of NJIT’s College of Science and Liberal Arts, “and the only university fortunate enough to be able to provide our students and industry partners the opportunity to take advantage of the process development, clinical manufacturing, and workforce development capabilities, as well as the experts and equipment resident at BioCentriq.”
In addition to the new degree program at NJIT, NJII is working with companies to create custom training programs for their workforces and any new hires. The program offers a unique opportunity for companies of all sizes to accelerate their workforce development.
Rowan University is also well established in translational research for cell and gene therapy since 2001, when the Cell & Gene Therapy Center (CGTC) was founded. CGTC combines both clinical and basic research facilities in a partnership with Cooper University Hospital and the Rowan University School of Osteopathic Medicine. It specializes in neurological diseases, ideal for studying the coronavirus’ impact on the blood-brain barrier. As it is also a translational research facility, the investigators utilize a multidisciplinary approach to the study of neurological diseases. They use numerous lab techniques to help develop applicable ways for gene transfer and cell transplantation treatments. The program has seen continued success, and even caught the eye of Pope Francis, who met with researcher Dr. Paola Leone in 2015 for her team’s work on Canavan Disease.
Opportunities for Young Companies in New Jersey
New Jersey is providing CGT companies an optimal environment to grow. The state works closely with incubator and accelerator programs to help stimulate opportunities for startups and spin-outs, such as Princeton Innovation Center Biolabs. At the Innovation Center, companies are given access to scalable shared office and lab space, and the opportunity to be a part of one of the world’s foremost academic epicenters. The New Jersey Bioscience Center, owned and run by the New Jersey Economic Development Authority, offers a multitude of lab and office space options for companies at all stages of growth.
There are many state programs supporting the life science industry:
- The Angel Investor Tax Credit Program provides refundable tax credits for qualifying investments into eligible early-stage life sciences and technology companies.
- The Net Operating Loss Program offers companies the ability to sell their net operating tax losses and R&D tax credits for cash.
- The New Jersey Small Business Innovation Research (SBIR) and Small Business Technology Transfer (STTR) Support Program is a $400,000 grant program offered by the New Jersey Commission on Science, Innovation and Technology.
- NJ Ignite provides rent support to life science and technology companies moving to participating collaborative workspaces.
New Jersey’s biopharma companies are shaping human health, with cell and gene therapy living on the bleeding edge. That’s why more than 50 percent of the Food and Drug Administration’s drug approvals in 2019 were from companies with a New Jersey footprint. New Jersey has been at the forefront of CGT research since the beginning, as the first two cell therapies originated within the state. From top talent to partnerships with our world-class universities and hospital systems, New Jersey is the ecosystem where any CGT company can innovate and find the support it needs.